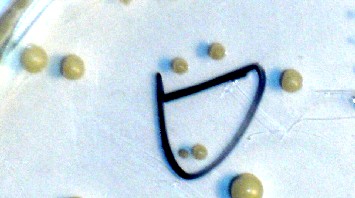

- Cycle 3
- 1ère ES
- 1ère L
- 2nde
- enseignant
- classe
Conservation des aliments
Une activité pratique réalisée en classe de 1ES sur le thème Nourrir l'humanité. Ce protocole permet d'approcher la biologie des micro-organismes, d'illustrer certaines techniques de conservation des aliments et peut être adapté à l'étude des DLC et DLUO.
Enfin, il s'intègre dans les enseignements d'exploration MPS et SL de seconde.

L'objectif est de modéliser par une activité pratique certaines techniques de conservation des aliments en utilisant des levures de boulanger comme "agent pathogène".
ATTENTION : Les conditions de manipulation avec des élèves sont soumises à une réglementation stricte (voir les textes officiels sur le site de Toulouse).
Activité pratique : cultures en condition stérile
Analyse des résultats par Mesurim
Activité pratique : cultures en condition stérile
Après avoir pris pour exemple les confitures, les salaisons ou l'action du froid, 1 ml d'une solution de levure de boulanger à 2 g.L-1 est mis en culture sur des géloses d'Agar différentes pendant 3 à 7 jours.
Les conditions de culture sont les suivantes :
| Boite | Milieu de culture | Température |
| Témoin | Glucose à 10 g.L-1 | 20°C (ambiante) |
| Froid | Glucose à 10 g.L-1 | 5°C (réfrigérateur) |
| Milieu sucré | Glucose ou saccharose à 40 g.L-1 | 20°C (ambiante) |
| Milieu salé | Glucose à 10 g.L-1 + sel de table à 40 g.L-1 | 20°C (ambiante) |
On obtient les résultats suivants:
Surface de la gélose vue à la loupe binoculaire
 Témoin G : x 10 |  Milieu salé G x 20 |
 Milieu sucré G x 20 | Froid G x 20 |
Analyse des résultats par Mesurim
:
Le logiciel mesurim permet d'évaluer la densité de colonies de levures sur les boites grâce à la fonction "Délimiter des zones".
Attention : il faut travailler sur les surfaces identiques et à la même échelle pour chaque image.

Il suffit alors de colorier quelques colonies sur l'image après avoir choisi une couleur et une épaisseur de trait.

Cliquez alors sur OK et on obtient la densité de colonies de levure sur la boite.

Après traitement dans un tableur, on obtient l'histogramme suivant (valeurs moyennes pour une classe) :

Remarques
Ce travail peut-être entièrement ou partiellement réalisé par les élèves.
Il permet également de rappeler certaines conditions d'hygiène (travail en condition stérile...) mais aussi de critiquer un modèle.
Ce protocole peut être adapté pour aborder les dates de péremption (DLC et DLUO) en réalisant des cultures de durée variable sur milieu classique.
